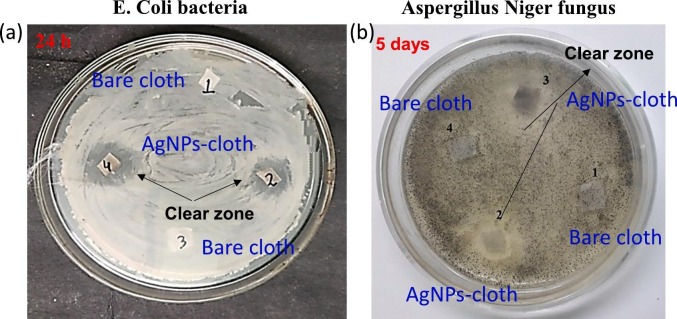
Fig. 7

Abstract
Surfaces containing antiviral nanoparticles could play a crucial role in minimizing the virus spread further, specifically for COVID-19. Here in, we have developed a facile and durable antiviral and antimicrobial fabric containing photodeposited silver nanoparticles. Scanning and transmission electron microscopy, UV-VIS spectroscopy, and XPS are used to characterize the silver nanoparticles deposited cloth. It is evident that Ag0/Ag+ redox couple is formed during fabrication, which acts as an active agent. Antiviral testing results show that silver nanoparticles deposited fabric exhibits 97% viral reduction specific to SARS-CoV-2. Besides its excellent antiviral property, the modified fabric also offers antimicrobial efficiency when tested with the airborne human pathogenic bacteria Escherichia coli and fungi Aspergillus Niger. The direct photodeposition provides Ag-O-C interaction leads to firmly grafted nanoparticles on fabric allow the modified fabric to sustain the laundry durability test. The straightforward strategy to prepare an efficient antimicrobial cloth can attract rapid large-scale industrial production.
Keywords: COVID-19, Anti-viral, Anti-bacterial, Anti-fungal, Silver nanoparticles `
Graphical abstract
1. Introduction
On 11th March 2020, World Health Organization (WHO) declared COVID-19 infection as a pandemic [1]. Since then, the SARS-CoV-2 virus has been spreading rapidly worldwide within a short time. Due to its highly contagious nature, millions of people are infected by this virus, resulting in millions of deaths and continuing. Furthermore, it is a new virus and has been undergoing mutations and evolving as new strains to which humans have not previously developed immunity – a common factor of a pandemic. New variants of SARS-CoV-2 have been confirmed in several countries/territories/areas. In modern history, a cruel example of a pandemic is an outbreak of the Spanish Flu in 1918–19, due to which 500 million people were infected and 100 million people have died [2]. Pandemics continue to remain a severe threat to humans at present.
Although some nations have recently started vaccines for COVID-19, such as BNT162b2 and mRNA-1273, WHO has not yet approved these vaccines for worldwide vaccination, also, the time required to achieve immunity in the vaccinated person is still hard to estimate. The longevity of immunity after vaccination is also not established. Furthermore, the vaccination of every individual in the world will require many years. The SARS-CoV-2 virus has a high propensity for genomic recombination and mutation, generating new strains, and the vaccine may not be equally efficient for each strain.
The main reason for this virus to create such a massive disaster in the world is its high contagious nature and ability to remain active on surfaces for long durations, sometimes up to several weeks [3]. However, the stability of SARS-CoV-2 on various surfaces can be reduced by altering the surface roughness & texture, temperature, humidity, and other environmental conditions [4]. One of the promising approaches besides vaccination is to inactivate the virus during its transmission through non-living objects, leading to a decrease in the spread of the contagious infection. The inactivation of the SARS-CoV-2 on the surface can be achieved by creating an antiviral and anti-pathogen coating on everyday inanimate objects. A few reports are recently published. Murti et al. demonstrated rapid inactivation of SARS-CoV-2 using a biofunctional coating of benzalkonium chloride [5]. A hydrophobic surface is developed by Kumar et al. using copper nanoparticles for photo-assisted anti-viral properties [6]. Carbon-based materials are also proposed as promising antiviral agents [7].
The growth of nanotechnology opens up new weapons for researchers. Nanoparticles are often reported for their antimicrobial activity and their low toxicity towards animal beings [[7], [8], [9], [10], [11], [12], [13]]. For example, silver nanoparticles (AgNPs) exhibited antimicrobial activity against several types of bacteria and fungi [48]. Antiviral activities of silver nanoparticles against viruses such as HIV-1 [14,15], hepatitis B [16], herpes simplex [17], respiratory syncytial [18], monkeypox [19], Tacaribe [20], and H1N1 influenza A virus [21,22] are previously reported. In general, the antiviral/antimicrobial mechanism of silver nanoparticles is found to be likely the physical inhibition of binding between the virus and host cell/surface. This property of AgNPs makes it the most promising candidate for the destruction of SARS-CoV-2 [,24]. It is also essential that besides the efficiency and durability, the developed surface should also be easily achievable via economic process. In this direction, photo-assisted deposition of AgNPs on cloth surface facilitated by photooxidation of fabric cellulose could be one of the most promising approaches [25]. The size of the AgNPs is also one of the major deciding parameters for the efficiency and durability of the developed surface [8,26,27]. AgNPs with a size of ~10 nm often reported to exhibit maximum antiviral efficiency [8,26,27].
The present study demonstrated that the AgNPs photodeposited cloth surfaces, effectively inhibit the growth of the SARS-CoV-2 virus, E. coli bacteria, and A. niger fungi. The characterization of the cloth unveils the size of AgNPs is ~10 nm, and it consists of Ag0 and Ag+. Most importantly, the silver nanoparticles AgNPs-cloth surface inhibited the SARS-CoV-2 propagation invitro by killing the virus.
2. Experimental details
2.1. Materials
Silver nitrate (Extra Pure) was purchased from HiMedia Laboratories Pvt. Ltd., India. Other chemicals were purchased from Avator Performance Materials India Limited (Rankem). All the chemicals were used without further purification. Cotton fabric cloth was procured from the local market (Dhanbad, India).
2.2. Formation of AgNPs on the cotton fabric surface
The cotton cloth was cut into the dimensions of 2 × 2 cm2 pieces, then washed several times ultrasonically in the mixture of acetone and distilled water, and finally dried. In a typical procedure (Fig. 1 ), the cleaned cotton cloth was immersed in an aqueous solution of 1 mM AgNO3 and kept under the UV lamp (wavelength 254 nm, irradiance 6.82 mW/cm2) for 30 min. Later, the cloth was removed from the solution and dried at 50 °C. The color of the cotton cloth was changed from white to dark brown. AgNPs-cloth was prepared successfully and was used for further experiments.
Fig. 1.
Schematic representation of the preparation of silver nanoparticles on cloth (AgNPs-cloth) via photo-deposition using UV irradiation.
2.3. Characterizations
The surface morphology of the samples was carried out using a scanning electron microscope (SEM, JEOL, JSM-6480LV). The elemental analysis of the samples was performed using X-ray Photo-Electron Spectroscopy (XPS) with Auger Electron Spectroscopy (AES) module and C60 sputter gun (PHI 5000 Versa Probe III, FEI Inc.). The UV-VIS-NIR Spectrophotometer (Agilent, Cary 500) was used to record absorption spectra. The High-Resolution Transmission Electron Microscope (HRTEM) (Thermo Scientific, Talos F200X G2) was used to obtain surface morphology.
The laundry test of the modified cloth was performed to study the washing durability [28]. In a typical process, a piece of cloth was dipped into an aqueous solution of laundry detergent and stirred for 1 h. The fabric was collected and washed with deionized water and dried at 50 °C in a hot-air oven. The experiment was repeated 5 times, and the washed fabric was characterized.
The bacterial interaction with the cloth samples was tested using the E. coli bacteria. Initially, the Mueller Hinton agar (Himedia) media was used as a culture medium for the test. The media was autoclaved and poured into the sterilized Petri plates for solidification. The E. coli bacteria (100 μl, fresh) were spread over the Petri plates. The samples were cut into an equal size square shape and placed on the agar petri plates. The plates were incubated at 37 °C for different time intervals like 1, 2, and 3 days. After incubation for regular intervals, images were taken and observed in the inhibition zone for all tested samples.
The fungi interaction was tested against the A. niger. The potato dextrose agar (PDA) media was used as a culture medium for fungal spore growth. The square shape samples were placed into the culture petri plates, and 100 μl of fresh fungi was spread over it. The plates were incubated at 25 °C for 5, 6, and 7 days. Images were taken, and the inhibition zone was measured.
2.4. Cell culture and viral infection on the AgNPs-cloth
Vero cells were maintained in Dulbecco Minimum Essential Medium (DMEM) (Gibco) containing 10% Fetal Bovine Serum (FBS) (Gibco) at 37 °C, 5% CO2. Cells were seeded into 96-well tissue culture plates 24 h prior to infection with SARS-CoV2 (Indian/a3i clade/2020 isolate) in a BSL3 laboratory.
The effect of silver nanoparticles on cloth surface was tested against the SARS-CoV-2 virus (ASTM E1052–20) at 30 and 60 min of contact with the virus. The AgNPs-cloth surface was co-incubated with the virus inoculum for 30 and 60 min along with the un-AgNPs- surface (control). After specified incubation time, the virus inoculum (0.1 MOI) was added to the vero cells and left for 3 h. Post-infection, the viral inoculum was replaced with fresh media containing 10% FBS and was maintained at 37 °C, 5% CO2, until 72 h. After 72 h, the cell supernatant was collected and spun for 10 min at 1000 rpm to remove debris, and the supernatant was transferred to fresh collection tubes.
2.5. Extraction of Viral RNA
The viral RNA was extracted from 200 μl aliquots of the experimental groups using MagMAX™ Viral/Pathogen Extraction Kit (Applied Biosystems, Thermofisher). The extraction of viral RNA was carried out following the manufacturer's instructions. The extracted viral supernatants from the test groups were added into the deep well plate (KingFisher™ Thermo Scientific) along with a lysis buffer containing the following components - MagMAX™ Viral/Pathogen Binding Solution; MVP-II Binding Beads; MagMAX™ Viral /Pathogen Proteinase-K of 260 lL; 10 μL; 5 μl respectively for 200 lL of the sample. RNA extraction was performed using KingFisher Flex (version 1.01, Thermo Scientific) as instructed by the manufacturer. The eluted RNA was immediately stored at -80 °C until further use.
2.6. Detection of SARS-CoV-2 using a TaqMan Real-time RT-PCR assay
The SARS-CoV-2 was detected using COVID-19 RT-PCR Detection Kit (Fosun 2019-nCoV qPCR, Shanghai Fosun Long March Medical Science Co. Ltd.) following the manufacturer's instructions [16,29]. The detection kit identifies the Envelope gene (E; ROX labeled), Nucleocapsid gene (N- JOE labeled), and open reading frame1ab (ORF1ab, FAM-labeled) specific to SARS-CoV-2. Briefly, RT-qPCR assays were performed using Quant studio Q5 (Thermo fisher). The assay details are as follows: 10 μl of Negative Control, 10 μl of Positive Control (positive and negative controls were provided by kit), and 10 μl of extracted RNA from samples were added in different PCR reaction tubes. The contents were centrifuged at low speed. The RT-qPCR was run using the following cycling conditions: Step 1: 50 °C for 15 min, 1 cycle; Step 2: 95 °C for 3 min, 1 cycle; Step 3: 95 °C for 5 s to 60 °C for 40 s, 5 cycles; Step 4: 95 °C for 5 s to 60 °C for 40 s, 40 cycles. The signals of FAM, JOE, ROX, and CY5 fluorescence channels were collected at 60 °C. SARS-CoV-2 cDNA (Ct ~ 28) was used as a positive control. The log viral particles and a semi-log graph were plotted using Graph Pad Prism 5 software (ver 5.03) through the linear regression equation obtained using the RNA extracted from the known viral particles by RT-qPCR, using N- and ORF1ab genes specific to SARS CoV-2 virus and percent viral reduction was calculated [30]. The Ct values of the N gene, E gene, and ORF 1ab were considered to estimate the % viral reduction and log viral particles.
3. Results and discussion
In this work, an antiviral (COVID-19) and antimicrobial coating on cloth surfaces have been developed by photo-depositing silver nanoparticles on its surface using UV irradiation (Fig. 1). This method is facile and does not require any additional reducing agent. When a cloth containing cellulose is irradiated by UV, the alcohol (-OH) groups present on the cloth work as a sacrificial oxidant and photo-oxidize into aldehyde (-CHO) groups, and they are converted into carboxylic acid (-COOH) groups, as shown in the Scheme 1 [25,31]. During photo-oxidation, free electrons are released, which subsequently reduce the Ag+ ion of AgNO3 to Ag0 and result in the deposition of AgNPs on the fabric surface (AgNPs-cloth).
Scheme 1.
Pathway for photo-deposition of silver nanoparticles on the cloth under UV irradiation.
The surface morphologies of bare and AgNPs-cloth were examined by the SEM (Fig. 2 ). The deposition of the AgNPs creates the roughness at the nanoscale via trapping of nanoparticles between the cellulose fibers, whereas these features are not observed on the bare sample.
Fig. 2.
SEM images of (a)bare cloth and (b) AgNPs-cloth. Right corners (inset) images are corresponding to the high magnification.
The AgNPs were separated by sonication of AgNPs-cloth in an ethanol solution and used for HRTEM analysis. Fig. 3 (a) displays the HRTEM images of spherical nanoparticles. The size distribution is plotted in Fig. 3 (b), indicating a wide range of particle size distribution with an average value of about 10 nm. The HRTEM image presented in the inset of Fig. 3 (b) shows the lattice d-spacing of about 0.23 nm corresponding to Ag (111), suggesting the formation of crystalline AgNPs [32]. EDS analysis was also carried out to examine the elemental information, and it confirms the presence of Ag (Fig. 3 (c)).
Fig. 3.
(a) HRTEM image, (b) particle size distribution, (inset b) lattice d-spacing, and (c) EDS analysis of silver nanoparticles obtained from the AgNPs-cloth.
The cloth samples were also analyzed by XPS (Fig. 4 ). The XPS survey (Fig. 4 (a)) indicates C, O, and Si in both AgNPs-cloth and bare cloth, where C and O correspond to the cellulose fiber. The survey spectrum of AgNPs-cloth also reveals the presence of Ag. The core-level high-resolution spectra of C1s electrons for cloth samples are depicted in Fig. 4 (b), including Gaussian curve fitting. The C1s spectrum of the bare cloth unveils three peaks at 284.5, 285.9, and 287.6 eV, corresponding to the C-H/C-C, C-OH, and C-O-C functionalities of cellulose, respectively [33]. A comparative broader C1s spectrum of AgNPs-cloth comprises three fitted peaks at 284.3, 285.6, and 287.7 eV. The two higher binding energy peaks are realized peak-broadening after AgNPs deposition under UV irradiation compared to bare cloth. The peak corresponding to C-OH functionality in bare cloth mainly represents the alcoholic group of cellulose, and it is partially converted to C-O-Ag and -COOH after photodeposition, which causes a peak shifting/broadening in the C1s spectrum. Similarly, the peak broadening and intensity increasing of 287.6 eV peak are due to the addition of C O (-COOH) functionality after coating.
Fig. 4.
(a) Survey XPS spectra and high-resolution core-level XPS spectra, (b) C1s, (c) O1s, and (d) Ag3d for cloth samples.
The high-resolution O1s XPS spectra of cloth samples are presented in Fig. 4 (c). Bare cloth shows a single peak at 531.4 eV, whereas the AgNPs-cloth shows two more peaks at 530.7 and 533.9. The peak at 531.4 eV corresponds to the cellulosic O. The peaks at 530.7 and 533.9 correspond to the carboxylic acids formed during coating and hydroxyl group, respectively [34]. The core-level high-resolution Ag 3d XPS spectrum, shown in Fig. 4 (d), confirms silver nanoparticles' presence on the AgNPs-cloth. The deconvolution (Gaussian peak fitting) of the obtained spectrum unveils the existence of Ag+ and Ag0 oxidation states with a peak separation of 0.9 eV. The peak at 367.3 eV corresponds to 3d5/2 of Ag+, and the peak at 368.2 eV represents the 3d5/2 of Ag0 [28,35]. The loss features corresponding to metallic silver are also observed to the higher binding energy of each spin-orbit component. From the corresponding peak ratio, the ratio of Ag0/Ag+ is approximate 2.3. The atomic % of Ag in the AgNPs-cloth is 0.5%, as indicated by XPS elemental composition analysis. Therefore, the significant peak alteration in C1s and O1s XPS spectra after coating confirms the mentioned mechanistic path in the Scheme 1. Due to photo-oxidation of cellulosic alcohol groups to an aldehyde, which further converts into the carboxylic acid group, is a cause of photo-reduction of Ag+ to Ag0 and formation of silver nanoparticles on cloth as confirm by the Ag3d XPS spectra.
The absorption spectra of AgNPs-cloth and bare cloth were also recorded in diffuse reflectance spectroscopy (DRS), and results are presented in Fig. 5 . The absorption spectrum of the AgNPs-cloth exhibits strong absorption of UV-VIS light, while the bare cloth has no significant light absorption. The light absorption in the UV and visible region suggests the presence of silver (Ag+) oxide and silver (Ag0) on the AgNPs-cloth, respectively [,36]. The broad absorption peak maxima at ~430 nm is observed for the surface plasmon resonance of AgNPs [36]. The excellent stability of the silver nanoparticles on cloth can be attributed to Ag—O interaction.
Fig. 5.
Absorption (DRS) spectra of cloth samples.
The laundry durability of the AgNPs-cloth was further examined by using regular liquid detergent. The XPS analysis (Fig. 6 (a) and (b)) of the washed AgNPs-cloth does not indicate any significant alteration compared to the pristine AgNPs-cloth (Fig. 4 (a) and (d)). The atomic % of Ag is 0.48% after wash. The absorption spectrum of the washed cloth was also recorded (Fig. 6 (c)). There is no significant change observed in absorption spectra after wash, which implies that coating has excellent laundry durability. The achieved durability of AgNPs-cloth is attributed to the strong interaction of AgNPs and cloth surface. As the silver nanoparticles formed on cloth surface itself during photodeposition, as shown in Scheme 1 , results in the firmly grafted nanoparticles. The Ag—O interaction as observed in XPS or UV-VIS analysis can evidence the statement.
Fig. 6.
(a) Survey, (b) Ag3d XPS spectrum, and (c) absorption (DRS) spectrum of AgNPs-cloth after wash.
The antibacterial susceptibility test was conducted on AgNPs-cloth using the disk diffusion method against the E. coli bacteria. For comparison, the bacterial test was also performed using the bare cloth. The results are presented in Fig. 7 (a). It shows an inhibition zone or no bacterial growth surrounding the AgNPs-cloth, whereas prominent bacterial growth is visible for the bare cloth. The inhibition zone was measured as a radius of no bacterial growth area, and the inhibition zone at different incubation times are tabulated in Table 1 . The inhibition zone after 1 day of incubation is found to be about 13 mm. Inhibition of bacteria in AgNPs-cloth occurs due to the presence of Ag0/Ag+ redox couple. Ag+ ions are electrostatically attracted to negatively charged lipopolysaccharides (LPS) present in the cell wall of E. coli bacteria, leading to nanoparticle adhesion to bacterial cell walls and membrane. This interaction alters the membrane morphology and permeability. As a result of changed membrane permeability and damaged cell wall, the cellular content (proteins, enzymes, DNA, ions, etc.) leak through the membrane leading to a decline in bacterial growth [[37], [38], [39]]. Besides, proteins present on the outer membrane of bacteria are made of O, N, P, S and exhibit electron donor tendency. Ag0/Ag+ redox couples interact with these proteins, resulting in the damage of the bacterial membrane. Additionally, thiol groups present in protein and enzymes interact with Ag+/Ag0 [40,41]. Further, it is also reported that Ag+ ion leads to transforming DNA from a naturally relaxed state to a condensed form, which leads to DNA losing its replication ability [38]. The inhibition zone is decreased to 10 mm after 2 days incubation and further reduced to 7 mm after 3 days incubation. The decrease of the inhibition zone is due to the decline in the number of active sites present on the AgNPs-cloth; i. e. over time, Ag0/Ag+ are already engaged in antibacterial activities, and a low number of active sites are only available for further antibacterial activities.
Fig. 7.
(a) Antibacterial activities of bare and AgNPs-cloth against E. coli for 1 day, using disk diffusion method. (b) Anti-fungal activities of bare and AgNP-cloth against A. niger for 5 days using disk diffusion method.
Table 1.
The inhibition zone for bare and AgNPs- samples at different time intervals against the E. coli bacteria.
| Incubation time (day) | Inhibition zone (mm) |
|
|---|---|---|
| Bare cloth | AgNPs-cloth | |
| Against the E. coli bacteria | ||
| 1 | – | 13 |
| 2 | – | 10 |
| 3 | – | 7 |
| Against the A. Niger fungus | ||
| 5 | – | 15 |
| 6 | – | 13 |
| 7 | – | 13 |
For anti-fungal contamination, a fungal susceptibility test was carried out using the disk diffusion method. Both bare and AgNPs-cloth were tested against the A. niger fungus. Fig. 7 (b) demonstrates the optical images of the petri disk of A. niger strain along with cloth samples. It is observed that fungi have grown on and around the bare cloth sample. No fungi have grown on and around the AgNPs-cloth, and an inhibition zone is prominent, demonstrating its anti-fungal activity. The observed inhibition zone at different incubation times is tabulated in Table 1. The inhibition zone after 5 days of incubation is found to be about 15 mm. Inhibition of fungi is due to the highly active Ag0/Ag+ redox couples present on the AgNPs- cloth. The highly active Ag+ ions can cause structural changes in hyphae of A. niger, deformation of the cell wall, membrane damage, change in spore formation, and germination [42], resulting in reduced fungal growth. Here also, the decrement of the inhibition zone was observed after 6 and 7 days incubation for the same reason.
The antiviral tests were performed using SARS-CoV-2 (Indian/a3i clade/2020 isolate) in a BSL3 lab. The test results reveal that the AgNPs-cloth sample confers the 95 and 97% viral reduction at 30 and 60 min contact time with the virus, respectively, concerning the detection of nucleocapsid gene (N-gene) through qRT PCR (Fig. 8 ). Furthermore, the application of the Envelope gene (E gene) and Open Reading Frame (ORF) specific to the SARS-Cov-2 virus showed more than 99% viral reduction at 30 and 60 min exposure with ~2 log viral reduction as compared with the untreated cloth (Fig. 8).
Fig. 8.
Graph showing increase in Viral Reduction (%) to a Log10 with SD (n = 2) for AgNPs-cloth. Viral particles at 30 and 60 min contact time with the SARS-CoV-2 viruses to the surface.
It is most likely that the antiviral nature of AgNP is due to the direct binding of AgNP to viral glycoprotein, leading to the virus death. The structure of SARS-CoV-2 comprises of exterior lipid membrane (M) with trimer glycoprotein spikes (S). These glycoprotein spikes are interspersed on the viral envelope (E). Glycoprotein spikes (S) are composed of two subunits: S1 and S2 (Fig. 9 ). S1 subunit contains N-terminal (NTD) and C-terminal (CTD) subdomains. The receptor-binding domain (RBD) is located in the CTD region [43,44]. In contrast, the S2 subunit is formed of a trimeric stalk and comprises a fusion peptide (FP) and two heptad repeats (HR1 and HR2), which operate the fusion of viral and host membranes [43,44]. The primary function of the S1 glycoprotein spikes is to bind the virus with receptor sites on the host cells/surface.
Fig. 9.
A schematic representation of the proposed mechanism of suppression of virus by the association of CTD and NTD (present on glycoprotein spikes) with active Ag0/Ag+ redox couple present on the AgNPs- fabric.
Although several other proteins are present on the viral envelope, glycoprotein spikes heads (S1 subunits) are more exposed to the exterior and possibly interact with Ag nanoparticles of AgNPs- cloth. It is reported that the S1 subunit has C-terminal (CTD) subdomains located in the vicinity of the receptor-binding domain [43,44]. Ag+ ions are electrostatically attracted with negatively charged CTD, and Ag0 may attract towards positively charged NTD, leading to viral spikes adhesion to the silver nanoparticles. Additionally, the virus membrane can also be damaged through Ag0/Ag+ interaction with the protein of the virus's outer membrane made of functionalities that contain O, N, P, S and prone to make bonding with Ag due to their electron donor tendency. This interaction alters the membrane morphology and permeability of the virus. As a result of changed membrane permeability and damaged cell wall, the cellular content (proteins, enzymes, DNA, ions, etc.) leak through the membrane and cell wall, leading to virus death [[45], [46], [47]].
4. Conclusions
The present study demonstrated the antiviral (COVID-19) and antimicrobial nature of the photo-deposited silver nanoparticles on the cloth surface. Different advanced characterization techniques like SEM, TEM, XPS, UV-VIS (DRS) have confirmed the formation of silver nanoparticles containing Ag0/Ag+ redox couple on the cloth surface. The modified cloth exhibited excellent laundry durability. Bactericidal and fungicidal properties of AgNPs-cloth have been examined against E. coli and A. niger, respectively. It demonstrated an excellent antibacterial and anti-fungal ability. Furthermore, virucidal properties of AgNPs-cloth against SARS-Cov-2 virus were also examined, and 97% efficiency was found. This formulation may be used in medical applications and manufacturing textile products of daily use to fight against COVID and other microbes.
Ethics approval statement
The Anti-SARS CoV-2 study was approved from Institutional Bio-safety Committee of CSIR-Centre for Cellular and Molecular Biology, Hyderabad, India.
Declaration of Competing Interest
The authors declare that they have no known competing financial interests or personal relationships that could have appeared to influence the work reported in this paper.
Acknowledgements
The authors are indebted to Prof. Rajeev Shekhar (Director, IIT (ISM) Dhanbad) for his kind help and support in coordinating the Virus testing. The authors are indebted to Miss Poonam Chauhan for her kind help during some experiments. The authors are indebted to the Central Research Facilities, IIT (ISM) Dhanbad for coating characterization. A.K. indebted to the FRS (IIT(ISM) Dhanbad), MRP (TEQIP-III, IIT(ISM) Dhanbad), and SERB-DST (Grant No. CRG/2018/001277) for financial support. B. K. K. would like to acknowledge financial support from Council of Scientific and Industrial Research (CSIR MLP0056). A.S. acknowledges the DST-INSPIRE Faculty scheme for fellowship and project funding (Grant No. IFA17-MS107). Ethics approval statement: The Anti-SARS CoV-2 study was approved from Institutional Bio-safety Committee of CSIR-Centre for Cellular and Molecular Biology, Hyderabad, India.
References
- 1.Cucinotta D., Vanelli M. WHO Declares COVID-19 a Pandemic. Acta Biomed. 2020;91:157–160. doi: 10.23750/abm.v91i1.9397. [DOI] [PMC free article] [PubMed] [Google Scholar]
- 2.Osterholm M.T. Preparing for the next pandemic. N. Engl. J. Med. 2005;352:1839–1842. doi: 10.1056/NEJMp058068. [DOI] [PubMed] [Google Scholar]
- 3.Van Doremalen N., Bushmaker T., Morris D.H., Holbrook M.G., Gamble A., Williamson B.N., Tamin A., Harcourt J.L., Thornburg N.J., Gerber S.I. Aerosol and surface stability of SARS-CoV-2 as compared with SARS-CoV-1. N. Engl. J. Med. 2020;382:1564–1567. doi: 10.1056/NEJMc2004973. [DOI] [PMC free article] [PubMed] [Google Scholar]
- 4.Chin A., Chu J., Perera M., Hui K., Yen H.-L., Chan M., Peiris M., Poon L. Stability of SARS-CoV-2 in different environmental conditions. MedRxiv. 2020;1(1):e10. doi: 10.1016/S2666-5247(20)30003-3. [DOI] [PMC free article] [PubMed] [Google Scholar]
- 5.Martí M., Tuñón-Molina A., Aachmann F.L., Muramoto Y., Noda T., Takayama K., Serrano-Aroca Á. Protective face mask filter capable of inactivating SARS-CoV-2, and methicillin-resistant Staphylococcus aureus and Staphylococcus epidermidis. Polymers. 2021;13:207. doi: 10.3390/polym13020207. [DOI] [PMC free article] [PubMed] [Google Scholar]
- 6.Kumar S., Karmacharya M., Joshi S.R., Gulenko O., Park J., Kim G.-H., Cho Y.-K. Photoactive antiviral face mask with self-sterilization and reusability. Nano Lett. 2021;21:337–343. doi: 10.1021/acs.nanolett.0c03725. [DOI] [PubMed] [Google Scholar]
- 7.Serrano-Aroca Á., Takayama K., Tuñón-Molina A., Seyran M., Hassan S.S., Pal Choudhury P., Uversky V.N., Lundstrom K., Adadi P., Palù G., Aljabali A.A.A., Chauhan G., Kandimalla R., Tambuwala M.M., Lal A., Abd El-Aziz T.M., Sherchan S., Barh D., Redwan E.M., Bazan N.G., Mishra Y.K., Uhal B.D., Brufsky A. Carbon-based nanomaterials: promising antiviral agents to combat COVID-19 in the microbial-resistant era. ACS Nano. 2021;15:8069–8086. doi: 10.1021/acsnano.1c00629. [DOI] [PubMed] [Google Scholar]
- 8.Mori Y., Ono T., Miyahira Y., Nguyen V.Q., Matsui T., Ishihara M. Antiviral activity of silver nanoparticle/chitosan composites against H1N1 influenza a virus. Nanoscale Res. Lett. 2013;8:93. doi: 10.1186/1556-276X-8-93. [DOI] [PMC free article] [PubMed] [Google Scholar]
- 9.Jiang T., Liu L., Yao J. In situ deposition of silver nanoparticles on the cotton fabrics. Fibers Polym. 2011;12:620. doi: 10.1007/s12221-011-0620-4. [DOI] [Google Scholar]
- 10.Thanh N.V.K., Phong N.T.P. Investigation of antibacterial activity of cotton fabric incorporating nano silver colloid. J. Phys. Conf. Ser. 2009;187 doi: 10.1088/1742-6596/187/1/012072. [DOI] [Google Scholar]
- 11.Firdhouse M.J., Lalitha P. Fabrication of antimicrobial perspiration pads and cotton cloth using <i>Amaranthus dubius</i> mediated silver nanoparticles. J. Chem. 2013;2013:741743. doi: 10.1155/2013/741743. [DOI] [Google Scholar]
- 12.Deng X., Nikiforov A. Yu, Coenye T., Cools P., Aziz G., Morent R., De Geyter N., Leys C. Antimicrobial nano-silver non-woven polyethylene terephthalate fabric via an atmospheric pressure plasma deposition process. Sci. Rep. 2015;5:10138. doi: 10.1038/srep10138. [DOI] [PMC free article] [PubMed] [Google Scholar]
- 13.Shrivastava S., Bera T., Singh S.K., Singh G., Ramachandrarao P., Dash D. Characterization of antiplatelet properties of silver nanoparticles. ACS Nano. 2009;3:1357–1364. doi: 10.1021/nn900277t. [DOI] [PubMed] [Google Scholar]
- 14.Elechiguerra J.L., Burt J.L., Morones J.R., Camacho-Bragado A., Gao X., Lara H.H., Yacaman M.J. Interaction of silver nanoparticles with HIV-1. J. Nanobiotechnol. 2005;3:6. doi: 10.1186/1477-3155-3-6. [DOI] [PMC free article] [PubMed] [Google Scholar]
- 15.Trefry J.C., Wooley D.P. Rapid assessment of antiviral activity and cytotoxicity of silver nanoparticles using a novel application of the tetrazolium-based colorimetric assay. J. Virol. Methods. 2012;183:19–24. doi: 10.1016/j.jviromet.2012.03.014. [DOI] [PubMed] [Google Scholar]
- 16.Lu L., Sun R., Chen R., Hui C.-K., Ho C.-M., Luk J.M., Lau G., Che C.-M. Silver nanoparticles inhibit hepatitis B virus replication. Antivir. Ther. 2008;13:253. [PubMed] [Google Scholar]
- 17.Baram-Pinto D., Shukla S., Perkas N., Gedanken A., Sarid R. Inhibition of herpes simplex virus type 1 infection by silver nanoparticles capped with Mercaptoethane sulfonate. Bioconjug. Chem. 2009;20:1497–1502. doi: 10.1021/bc900215b. [DOI] [PubMed] [Google Scholar]
- 18.Sun L., Singh A.K., Vig K., Pillai S.R., Singh S.R. Silver nanoparticles inhibit replication of respiratory syncytial virus. J. Biomed. Nanotechnol. 2008;4:149–158. [Google Scholar]
- 19.Rogers J.V., Parkinson C.V., Choi Y.W., Speshock J.L., Hussain S.M. A preliminary assessment of silver nanoparticle inhibition of monkeypox virus plaque formation. Nanoscale Res. Lett. 2008;3:129–133. [Google Scholar]
- 20.Speshock J.L., Murdock R.C., Braydich-Stolle L.K., Schrand A.M., Hussain S.M. Interaction of silver nanoparticles with Tacaribe virus. J. Nanobiotechnol. 2010;8:19. doi: 10.1186/1477-3155-8-19. [DOI] [PMC free article] [PubMed] [Google Scholar]
- 21.Mehrbod P., Motamed N., Tabatabaeian M., Soleymani E.R., Amini E., Shahidi M., Kheyri M. 2009. In Vitro Antiviral Effect Of. [Google Scholar]
- 22.Xiang D.-x., Chen Q., Pang L., Zheng C.-l. Inhibitory effects of silver nanoparticles on H1N1 influenza a virus in vitro. J. Virol. Methods. 2011;178:137–142. doi: 10.1016/j.jviromet.2011.09.003. [DOI] [PubMed] [Google Scholar]
- 24.Balagna C., Perero S., Percivalle E., Nepita E.V., Ferraris M. Virucidal effect against coronavirus SARS-CoV-2 of a silver nanocluster/silica composite sputtered coating. Open Ceramics. 2020;1:100006. doi: 10.1016/j.oceram.2020.100006. [DOI] [Google Scholar]
- 25.Omrani A.A., Taghavinia N. Photo-induced growth of silver nanoparticles using UV sensitivity of cellulose fibers. Appl. Surf. Sci. 2012;258:2373–2377. doi: 10.1016/j.apsusc.2011.10.038. [DOI] [Google Scholar]
- 26.Bekele A.Z., Gokulan K., Williams K.M., Khare S. Dose and size-dependent antiviral effects of silver nanoparticles on feline Calicivirus, a human norovirus surrogate. Foodborne Pathog. Dis. 2016;13:239–244. doi: 10.1089/fpd.2015.2054. [DOI] [PubMed] [Google Scholar]
- 27.Guzman M., Dille J., Godet S. Synthesis and antibacterial activity of silver nanoparticles against gram-positive and gram-negative bacteria. Nanomedicine. 2012;8:37–45. doi: 10.1016/j.nano.2011.05.007. [DOI] [PubMed] [Google Scholar]
- 28.Xing H., Cheng J., Tan X., Zhou C., Fang L., Lin J. Ag nanoparticles-coated cotton fabric for durable antibacterial activity: derived from phytic acid–ag complex. J. Textile Institute. 2020;111:855–861. doi: 10.1080/00405000.2019.1668137. [DOI] [Google Scholar]
- 29.W.H. Organization . 2020. Clinical Management of Severe Acute Respiratory Infection when Novel Coronavirus (nCoV) Infection Is Suspected, Interim Guidance, 13 March 2020. [Google Scholar]
- 30.Caly L., Druce J.D., Catton M.G., Jans D.A., Wagstaff K.M. The FDA-approved drug ivermectin inhibits the replication of SARS-CoV-2 in vitro. Antivir. Res. 2020;178:104787. doi: 10.1016/j.antiviral.2020.104787. [DOI] [PMC free article] [PubMed] [Google Scholar]
- 31.Isogai A., Hänninen T., Fujisawa S., Saito T. Review: catalytic oxidation of cellulose with nitroxyl radicals under aqueous conditions. Prog. Polym. Sci. 2018;86:122–148. doi: 10.1016/j.progpolymsci.2018.07.007. [DOI] [Google Scholar]
- 32.Yang P., Xu Y., Chen L., Wang X., Mao B., Xie Z., Wang S.-D., Bao F., Zhang Q. Encapsulated silver nanoparticles can be directly converted to silver Nanoshell in the gas phase. Nano Lett. 2015;15:8397–8401. doi: 10.1021/acs.nanolett.5b04328. [DOI] [PubMed] [Google Scholar]
- 33.Pothan L.A., Simon F., Spange S., Thomas S. XPS studies of chemically modified Banana fibers. Biomacromolecules. 2006;7:892–898. doi: 10.1021/bm050462a. [DOI] [PubMed] [Google Scholar]
- 34.Tawil N., Sacher E., Boulais E., Mandeville R., Meunier M. X-ray photoelectron spectroscopic and transmission Electron microscopic characterizations of bacteriophage–nanoparticle complexes for pathogen detection. J. Phys. Chem. C. 2013;117:20656–20665. doi: 10.1021/jp406148h. [DOI] [Google Scholar]
- 35.Jiang Z., Xie J. In situ growth of ag/ag 2 O nanoparticles on gC 3 N 4 by a natural carbon nanodot-assisted green method for synergistic photocatalytic activity. RSC Adv. 2016;6:3186–3197. [Google Scholar]
- 36.Hu X., Hu C., Wang R. Enhanced solar photodegradation of toxic pollutants by long-lived electrons in ag–Ag2O nanocomposites. Appl. Catal. B Environ. 2015;176-177:637–645. doi: 10.1016/j.apcatb.2015.04.040. [DOI] [Google Scholar]
- 37.Roy A., Bulut O., Some S., Mandal A.K., Yilmaz M.D. Green synthesis of silver nanoparticles: biomolecule-nanoparticle organizations targeting antimicrobial activity. RSC Adv. 2019;9:2673–2702. doi: 10.1039/C8RA08982E. [DOI] [PMC free article] [PubMed] [Google Scholar]
- 38.Feng Q.L., Wu J., Chen G.Q., Cui F.Z., Kim T.N., Kim J.O. A mechanistic study of the antibacterial effect of silver ions on Escherichia coli and Staphylococcus aureus. J. Biomed. Mater. Res. 2000;52:662–668. doi: 10.1002/1097-4636(20001215)52:4<662::aid-jbm10>3.0.co;2-3. [DOI] [PubMed] [Google Scholar]
- 39.Abbaszadegan A., Ghahramani Y., Gholami A., Hemmateenejad B., Dorostkar S., Nabavizadeh M., Sharghi H. The effect of charge at the surface of silver nanoparticles on antimicrobial activity against gram-positive and gram-negative Bacteria: a preliminary study. J. Nanomater. 2015;2015:720654. doi: 10.1155/2015/720654. [DOI] [Google Scholar]
- 40.Liau S.Y., Read D.C., Pugh W.J., Furr J.R., Russell A.D. Interaction of silver nitrate with readily identifiable groups: relationship to the antibacterial action of silver ions. Lett. Appl. Microbiol. 1997;25:279–283. doi: 10.1046/j.1472-765x.1997.00219.x. [DOI] [PubMed] [Google Scholar]
- 41.Holt K.B., Bard A.J. Interaction of silver(I) ions with the respiratory chain of Escherichia coli:an electrochemical and scanning electrochemical microscopy study of the antimicrobial mechanism of micromolar ag+ Biochemistry. 2005;44:13214–13223. doi: 10.1021/bi0508542. [DOI] [PubMed] [Google Scholar]
- 42.Ouda S.M. Antifungal activity of silver and copper nanoparticles on two plant pathogens, Alternaria alternata and Botrytis cinerea. Res. J. Microbiol. 2014;9:34. [Google Scholar]
- 43.Walls A.C., Park Y.-J., Tortorici M.A., Wall A., McGuire A.T., Veesler D. Structure, function, and antigenicity of the SARS-CoV-2 spike glycoprotein. Cell. 2020;181 doi: 10.1016/j.cell.2020.02.058. 281–292. e286. [DOI] [PMC free article] [PubMed] [Google Scholar]
- 44.Hoffmann M., Kleine-Weber H., Schroeder S., Krüger N., Herrler T., Erichsen S., Schiergens T.S., Herrler G., Wu N.-H., Nitsche A., Müller M.A., Drosten C., Pöhlmann S. SARS-CoV-2 cell entry depends on ACE2 and TMPRSS2 and is blocked by a clinically proven protease inhibitor. Cell. 2020;181 doi: 10.1016/j.cell.2020.02.052. 271–280.e278. [DOI] [PMC free article] [PubMed] [Google Scholar]
- 45.Lara H.H., Ayala-Nuñez N.V., Ixtepan-Turrent L., Rodriguez-Padilla C. Mode of antiviral action of silver nanoparticles against HIV-1. J. Nanobiotechnol. 2010;8:1. doi: 10.1186/1477-3155-8-1. [DOI] [PMC free article] [PubMed] [Google Scholar]
- 46.Jeremiah S.S., Miyakawa K., Morita T., Yamaoka Y., Ryo A. Potent antiviral effect of silver nanoparticles on SARS-CoV-2. Biochem. Biophys. Res. Commun. 2020;533:195–200. doi: 10.1016/j.bbrc.2020.09.018. [DOI] [PMC free article] [PubMed] [Google Scholar]
- 47.Sharmin S., Rahaman M.M., Sarkar C., Atolani O., Islam M.T., Adeyemi O.S. Nanoparticles as antimicrobial and antiviral agents: a literature-based perspective study. Heliyon. 2021;7 doi: 10.1016/j.heliyon.2021.e06456. [DOI] [PMC free article] [PubMed] [Google Scholar]
- 48.Suresh Kumar Kailasa, Tae-Jung Park, JigneshkumarRohit V. Alexandru Mihai Grumezescu, Nanoparticles in Pharmacotherapy. William Andrew Publishing; 2019. Janardhan Reddy Koduru,Chapter 14 - Antimicrobial activity of silver nanoparticles; pp. 461–484. ISBN 9780128165041. [DOI] [Google Scholar]